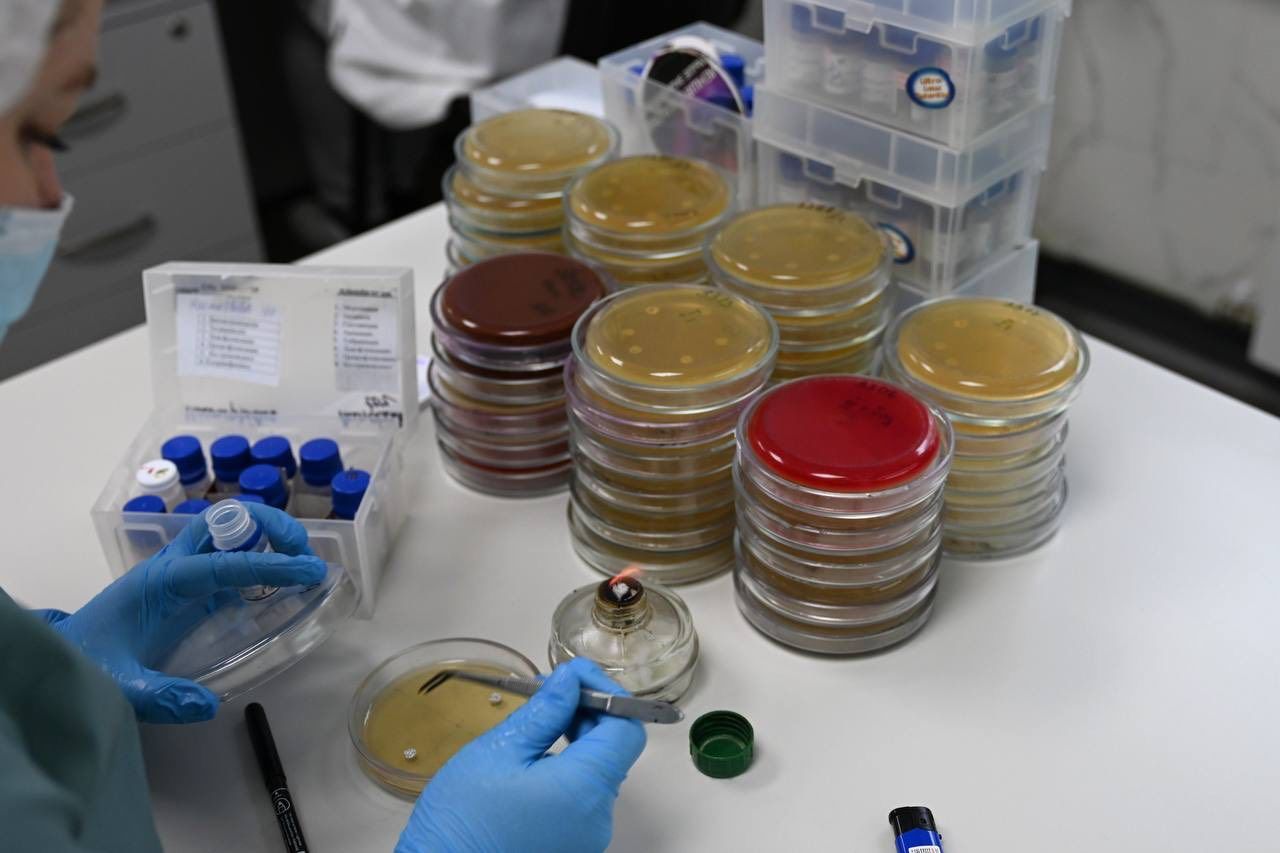

Пархоменко Валерій: у Полтаві працює міська бактеріологічна лабораторія
У Полтаві працює бактеріологічна лабораторія. Це міський комунальний заклад. Тож за електронним направленням обстеження можна пройти безкоштовно. Сучасне обладнання дозволяє проводити такі дослідження, які раніше робили тільки приватні лабораторії.
Важливий момент — швидкість. Весь процес відбувається тут і зараз. Зразки, які надходять, беруть у роботу вже протягом 15 хвилин, а не везуть кудись в інше місто.
Щоб підвищити якість життя людей, потрібно створити такі умови, щоб жити у Полтаві було безпечно, комфортно та затишно. Потрібно продовжувати будувати укриття, щоб захистити людей. Покращувати дитячі садочки та школи. Створювати умови для розвитку дітей і молоді. Навести лад у дворах та будинках. Сприяти розвитку підприємств, щоб забезпечити людей роботою. Оновити рухомий склад міського транспорту. Зробити наші парки і сквери зручними та комфортними для відпочинку. Підвищити рівень обслуговування населення та покращити якість надання соціальних послуг.

Разом із вами, шановні мешканці Полтави, ми обовʼязково зможемо це все зробити.
Сьогодні і завжди потрібно берегти своє здоров’я. Вчасно звертатися до лікарів. Проходити періодичні обстеження. Потурбуйтесь про себе і своїх близьких.
Телефон централізованої міської лабораторії: (0532) 68-83-81.
Валерій ПАРХОМЕНКО